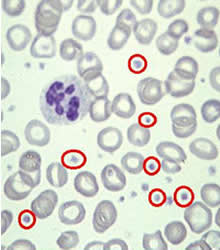
頭孢匹林鈉

藥物名稱
 頭孢匹林鈉
頭孢匹林鈉吡硫頭孢菌素鈉、頭孢吡硫鈉、頭孢菌素Ⅷ 、頭孢匹林鈉
Cefapirin Sodium
藥理作用
 頭孢匹林鈉對肺炎球菌的作用
頭孢匹林鈉對肺炎球菌的作用本品抗菌譜及抗菌作用與頭孢唑啉鈉相似,對β內醯胺酶較穩定,對肺炎球菌、腸球菌有高效。頭孢匹林鈉為β-內醯胺類廣譜抗生素。除腸球菌、耐甲氧西林和耐青黴素的金黃色葡萄球菌外,對其它革蘭陽性球菌與常見的革蘭陰性桿菌均有較強抗菌作用;對革蘭陽性球菌的作用超過第二代與第三代頭孢菌素;對革蘭陰性桿菌的作用,在第一代頭孢菌素中居首位,但不及第二代頭孢菌素,更不如第三代頭孢菌素。本品對陰性桿菌產生的β-內醯胺酶不穩定,故已有不少陰性桿菌對本品耐藥;頭孢匹林鈉對銅綠假單胞菌、腸桿菌屬桿菌與厭氧菌均無抗菌活性。李斯特菌屬、衣原體、艱難梭菌、脆弱擬桿菌等對本品耐藥。第一代頭孢菌素對革蘭陰性菌的β-內醯胺酶的抵抗力較弱,因此,革蘭陰性菌對本代抗生素較易耐藥。第一代頭孢菌素對吲哚陽性變形桿菌、枸櫞酸桿菌、產氣桿菌、假單胞菌、沙雷桿菌、擬桿菌、糞鏈球菌(頭孢硫脒除外)等微生物無效。本代抗生素中常用品種有頭孢唑林、頭孢氨苄、頭孢拉定、頭孢羥氨苄、頭孢克羅等。其中除頭孢唑林只能供注射外,其他的均可用於口服,也稱口服頭孢。頭孢噻吩、頭孢噻啶、頭孢來星、頭孢乙腈、頭孢匹林等均已少用或不用。
動力學
與頭孢噻吩類似,肌內注射時疼痛,多採用靜脈注射。本品雖組織分布廣,但即使有炎症時,腦脊液中血藥濃度仍未達治療水平。血漿蛋白結合率約為50%,部分在體內代謝,原藥與代謝物均經腎臟徘泄,主要由腎小管分泌,丙磺舒可抑制其分泌,體內半衰期為30~50min,腎功能不全者會延長,劑量應相應調整。藥動學:頭孢匹林鈉口服後吸收很差。肌內注射0.5g和1g,30分鐘後血藥濃度達峰值,分別為10μg/mL和20μg/mL,4小時後血藥濃度迅速下降。靜脈注射1g,15分鐘後血藥濃度為30-60μg/mL,如每6小時靜脈注射3g,血藥峰濃度為150-200μg/mL。藥物吸收後分布廣泛,在腎皮質、胸水、心肌、橫紋肌、皮膚、胃等組織的濃度較高,除腎臟中濃度接近血藥濃度外,其餘組織中的濃度僅為血藥濃度的1/3左右,肝和大腦中的藥物濃度分別為血藥濃度的10%和2%。本品很難滲透至正常腦脊液,但靜脈注射2g後,腦組織中的濃度足以抑制敏感的革蘭陽性球菌。在腦膜炎病人腦脊液中藥物濃度為血清濃度的1-10%。膽汁中藥物濃度低於同期血藥濃度。本品可透過胎盤,胎兒血循環中濃度約為母體血藥濃度的10-15%。乳汁中濃度約為血藥濃度的30%。頭孢匹林鈉的分布容積為0.26L/kg,蛋白結合率為50-65%,半衰期為0.5-0.8小時,腎功能減退時可延長至3-8小時,1周內新生兒的半衰期為1-2小時。頭孢匹林鈉在肝內約20-30%迅速代謝成為去乙醯頭孢匹林鈉。約60-70%的給藥量於6小時內通過腎小管分泌隨尿液排泄,肌注0.5和1g後尿中峰濃度可分別達800和2500μg/mL。另有少量(約0.03%)藥物隨膽汁排泄。
適應症
 頭孢匹林鈉治療心內膜炎
頭孢匹林鈉治療心內膜炎泌尿生殖系統的感染和胸膜炎、敗血症,嚴重葡萄球菌感染的心內膜炎等
1、呼吸道感染。
2、尿路感染。
3、肝膽系統感染。
4、預防手術後感染(如髖關節形成術、心臟手術和膽囊切除術等)。
5、眼、耳鼻喉科感染。
6、皮膚、軟組織感染。
7、骨、關節感染,如骨髓炎。
8、其它嚴重感染,如敗血症、感染性心內膜炎等。
用量用法
肌注或靜注,也可靜滴。1日2~6g,重症可用到12g,分2~4次。
成人:2-68/d,分3-4次給予;兒童:每日每千克體重50-80mg,分次給予。
注意事項
1、交叉過敏:病人對一種頭孢菌素或頭黴素(cephamycin)過敏者對其它頭孢菌素或頭黴素也可能過敏。病人對青黴素類、青黴素衍生物或青黴胺過敏者也可能對頭孢菌素或頭黴素過敏。
2、禁忌症:對本品或其它頭孢菌素類藥物過敏的患者禁用。
3、慎用:(1)對青黴素類抗生素過敏的患者慎用。(2)頭孢匹林鈉對孕婦、哺乳期婦女的用藥安全性尚未確定,故孕婦、哺乳期婦女應慎用。(3)早產兒、新生兒慎用。(4)有胃腸道疾病病史者,特別是潰瘍性結腸炎、局限性腸炎或抗生素相關性結腸炎者應慎用。(5)嚴重肝、腎功能障礙患者慎用。(6)高度過敏性體質、高齡體弱患者慎用。
4、其它注意事項
(1)直接抗人球蛋白試驗(Coombs試驗)呈陽性反應。
(2)以硫酸銅法測定尿糖可呈假陽性。
(3)少數患者用藥後可出現血清丙氨酸氨基轉移酶、乳酸脫氫酶、門冬氨酸氨基轉移酶、鹼性磷酸酶和血尿素氮測定值升高。
(4)在套用頭孢匹林鈉過程中,如採用Jaffe反應進行血清和尿肌酐值測定時可有假性增高。
(5)少數患者用藥後偶可出現血色素、血小板減少,中性粒細胞減少,嗜酸性粒細胞增多,蛋白尿、少尿等。
(6)長期用藥時應常規檢查肝、腎功能及血、尿常規。
(7)有肝、腎功能損害患者使用本品時應進行血藥濃度監測。
給藥說明
過敏反應血小板減少
過敏反應血小板減少1、有青黴素類藥過敏史的患者,使用頭孢匹林鈉時須進行皮試。如遇休克反應,可按青黴素G過敏性休克處理方法處理。
2、藥物過量時,血液透析有助於清除部分藥物(6小時後血藥濃度可減少40-45%)。腹膜透析一般不能清除本品。
3、本品水溶液較穩定,室溫下可保存24小時,受冷常析出結晶,宜溫熱溶化後套用。
4、肌內注射液,分別加2mL和2.5mL滅菌注射用水或氯化鈉注射液於500mg或1g注射用頭孢匹林鈉中。
靜脈注射液,將0.5或1g頭孢唑林鈉溶於10mL滅菌注射用水中,作徐緩靜脈注射(3-5分鐘);靜脈滴注時再用100mL稀釋液稀釋後靜滴。
治療優勢
 頭孢匹林鈉
頭孢匹林鈉據4月《兒科》雜誌(pediatrics2004;113:866-882)上的一項報告,頭孢匹林鈉對鏈球菌性扁桃體咽炎的細菌學和臨床治癒效果好於青黴素。
作者、紐約羅徹斯特大學的皮奇徹羅(michaele.pichichero)和凱西(janetr.casey)解釋,上世紀90年代早期的薈萃分析總結說,頭孢匹林鈉在清除急症患兒的a組β-溶血性鏈球菌(gabhs)方面較好。這以後,共發表了22個新的臨床對照試驗(兒童的)。他們對所有這些隨機、對照試驗又進行了一次嚴密的薈萃分析,以比較頭孢匹林鈉和青黴素治療gabhs性扁桃體咽炎患兒的效果。
35個試驗共涉及7125名兒童。作者報告,頭孢匹林鈉清除細菌的可能比青黴素大3倍,臨床治癒的可能大2.4倍。而且在這兩方面,三代頭孢匹林鈉都優於青黴素。
“青黴素治療確實可能失敗,而且很常見”,凱西告訴路透社記者,“而使用頭孢匹林鈉,特別是第一代,清除細菌的可能較大”。“對培養證實為gabhs感染的扁桃體咽炎患兒,尤其是本年內已發作過的……我支持使用頭孢匹林鈉”,“醫生們要知道並承諾減少不正確地使用抗生素,以免產生耐藥性細菌”。“最後,在治療前要通過培養物來證實gabhs,並使用最窄抗菌譜的抗生素。對病人來說,最有效的治療就是最好的”。
副反應案例
隨著第三代頭孢菌素的廣泛套用,在臨床上出現的不良反應日漸增多,頭孢匹林鈉等致戒酒硫樣反應時有發生。
含有硫甲基四氮唑基團的頭孢匹林鈉有類似戒酒硫樣的功能,當與乙醇(即使很少量)聯合套用時也會引起體內乙醛蓄積中毒,出現不良反應。陳新謙等主編的《新編藥物學》(14版)稱這種中毒表現為“醉酒狀”。戒酒硫又稱雙硫侖,能抑制乙醛脫氫酶,使飲酒者體內乙醛蓄積,產生難受反應而用於戒酒。1998年,張寧新等報導,頭孢匹林鈉致戒酒硫樣反應2例,其典型反應是:飲酒5~10分鐘,面色猩紅,面部發熱,頭痛,嚴重者呼吸困難,出汗,口乾,血壓下降,虛脫,煩躁不安,甚至因休克、呼吸抑制、心肌梗死、急性心衰、驚厥而死亡。近來有報導,某一縣級醫院從1998年1月~2000年12月收治了因使用頭孢哌酮所致戒酒硫樣反應31例,均在靜脈滴注頭孢哌酮中或治療後出現不良反應,其中面色潮紅31例,面部發熱28例,頭痛24例,胸悶21例,心悸19例,氣促及口乾各9例,煩躁不安8例,出汗、低血壓、心絞痛和心電圖ST—T改變各4例。其中31例中出現不良反應數分鐘前飲酒者25例,其餘6例雖未飲酒,但在頭孢哌酮治療期間有多次使用乙醇消毒皮膚史,可見少量乙醇經皮膚也可進入血液循環,出現戒酒硫樣反應。
臨床使用的頭孢哌酮中含有硫甲基四氮唑基團,其他如頭孢甲肟、頭黴素類及氧頭孢烯類均含有該基團,但臨床套用較少,因而此種不良反應不易見到。鑒於目前不少臨床藥物手冊及頭孢哌酮的國內產品說明書中均未述及此類不良反應,有些醫護人員又知道甚少,因此,在臨床套用頭孢匹林鈉類,尤其是含有硫甲基四氮唑基團的頭孢哌酮時,應囑告病人在用藥前或用藥期間均勿飲酒或食用含酒精的飲料與糖果,還應注意不要多次使用酒精消毒皮膚或使用酒精擦洗降溫,以防引起戒酒硫樣不良反應,尤其是心血管病患者更應注意。
相關詞條
頭孢氨苄、頭孢拉定、頭孢羥氨苄、頭孢克羅、頭孢噻吩、頭孢噻啶、頭孢來星、頭孢乙腈

